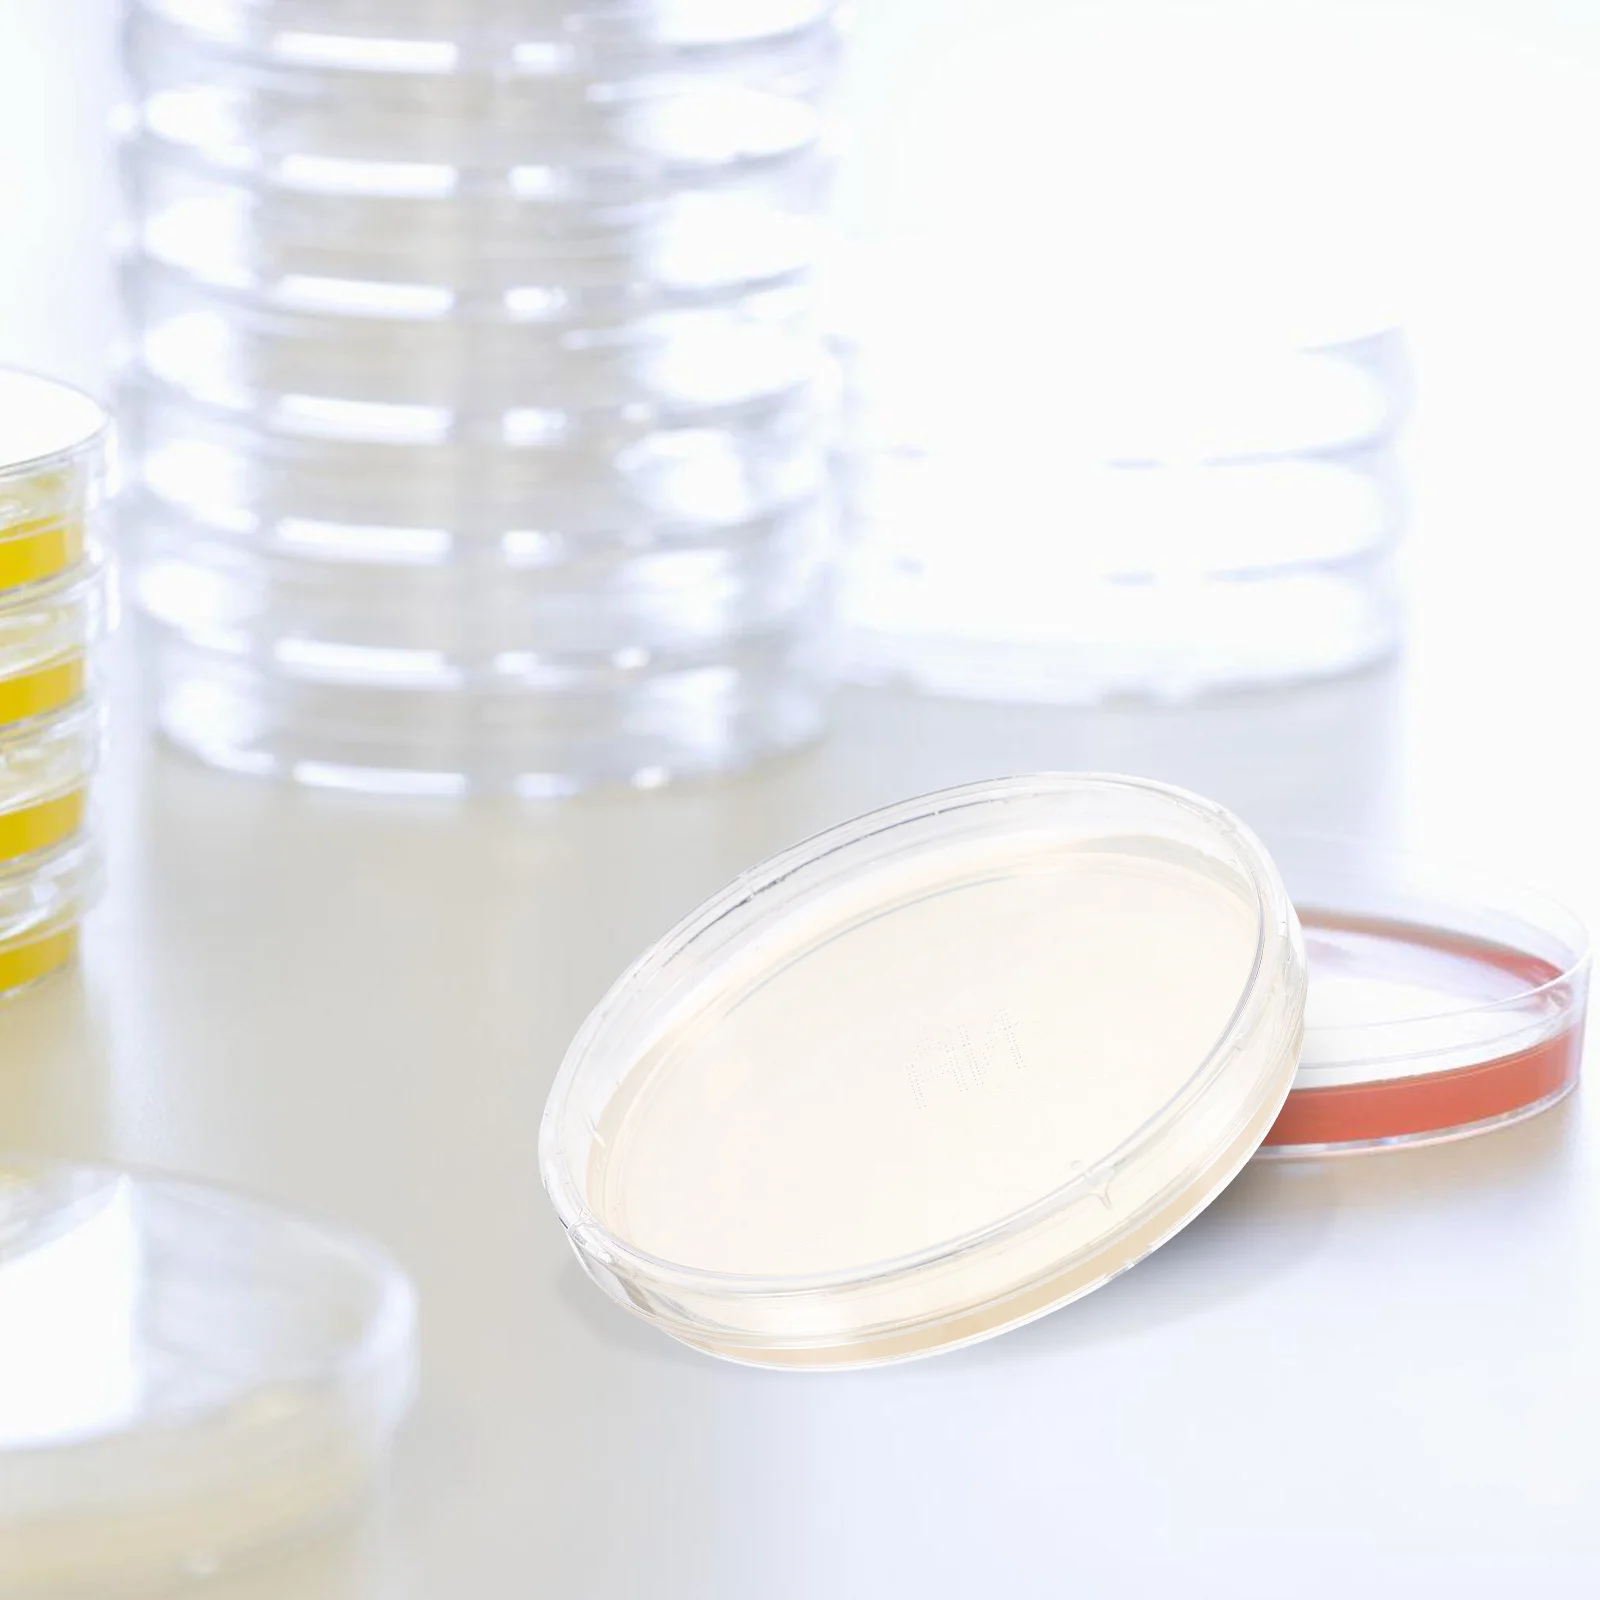
10Pcs Agar Plates for Laboratory Portable Prepoured Petri Dishes Bacteria Experiment Tool Lab Agar Plate
10Pcs Agar Plates for Laboratory Portable Prepoured Petri Dishes Bacteria Experiment Tool Lab Agar Plate

Автомобильная краска KIWIX VOLVO 449 MISTRAL GREEN/GOLD GREY 500 мл/449-057255B, Золотой, VOLVO 449 MISTRAL GREEN/GOLD GREY 500 мл

KIWIX
sku: 100033253843
ACCORDING TO OUR RECORDS THIS PRODUCT IS NOT AVAILABLE NOW
1,161.00 руб.
Shipping from: Russia
Description
Краска наливается по заводскому коду краски автомобиля и закачивается в аэрозольный баллон.
- Используется для локального ремонта.
- Для лучшего результата при нанесении нужно обезжирить поверхность и нанести грунт, после высыхания грунта нанести краску (перед применением нужно встряхнуть содержимое баллона не менее 1 минуты), после высыхания краски нанести лак.
- Укрываемость краски 2-4 слоя в зависимости от цвета.
- Изготовленный цвет может отличаться от вашего цвета (способ нанесения, выцветание и отсутствие подбора).
Внимание! Применять при температуре не ниже + 5 градусов по Цельсию.
- Используется для локального ремонта.
- Для лучшего результата при нанесении нужно обезжирить поверхность и нанести грунт, после высыхания грунта нанести краску (перед применением нужно встряхнуть содержимое баллона не менее 1 минуты), после высыхания краски нанести лак.
- Укрываемость краски 2-4 слоя в зависимости от цвета.
- Изготовленный цвет может отличаться от вашего цвета (способ нанесения, выцветание и отсутствие подбора).
Внимание! Применять при температуре не ниже + 5 градусов по Цельсию.
Technical Details
| Color: | золотой |
Price history chart & currency exchange rate
Customers also viewed

116.66 руб.
Seaside Summer Beach Vacation Retro Handbag Straw Woven Magnetic Buckle Stitching Color Matching Bucket Black White Handle Bag
aliexpress.com
1,527.86 руб.
A4 Vlad Print Backpack Boys Girls Large Capacity 18inch Teen Student School Bag Laptop Backpack Travel Backpack
aliexpress.com
17,306.11 руб.
New original 6ES7134-6JD00-0CA1 6ES7135-6HD00-0BA1 6ES7137-6AA00-0BA0 6ES7138-6AA01-0BA0 spot
aliexpress.com
13,420.08 руб.
CO60RGBW led industrial automation equipment glass appearance scratch detection lighting machine vision coaxial light source
aliexpress.com
1,420.85 руб.
10X Car Stereo Audio 16 PIN Android Power Wiring Harness Adaptor For KIA Carens K2/K3/K4/K5 Hyundai IX35 Elantra Sonata
aliexpress.com
1,873.02 руб.
2021 TARCHIA Autumn Outerwear Sportwear Hoodies Lip Logo Pullover Hoodies Mens Long Sleeve Casual Sweatshirts Women 0709022
aliexpress.com
1,072.48 руб.
Rocket League Throw Blanket fur Throw Blanket cute blanket plaid blankets for baby
aliexpress.com
883.41 руб.
Xiao Zhan Wang Yibo косплей перчатки Bo Jun Yi Xiao повседневные теплые милые аксессуары для костюма аксессуары для фанатов подарок
aliexpress.com
4,196.59 руб.
Teruko Okura Cosplay Costume Wig Anime Bungou Stray Dogs Season 4th Hunting Dogs Women Uniform Suehiro Cloak Ochi Fukuchi Wig
aliexpress.com
1,243.85 руб.
Браслет из киновари мужские и женские мужские Benmingnian Fu персонажи S925 Стерлинговое Серебро в китайском стиле счастливый жемчуг
aliexpress.com
223.67 руб.
Горячая Распродажа, Чистящая Щетка для автомобиля, аксессуары для Mazda 2, 3, 5, 6
aliexpress.com
557.56 руб.
Mr Mrs Printing Couple Sportswear Set Lovers Clothes Fleece Suit Men Women Hoodie and Pants 2 PCs Solid Color Couple Outfits
aliexpress.com
7,965.15 руб.
Watch Hand Removing Pry Levers Set of 10pcs Watch Hairspring Collet Levers
aliexpress.com
370.90 руб.
For Honda CB1000R 2010-2022 2021 2020 2019 CB 1000 R CB1000 1000R Motorcycle Keychain Keyring Protect Key Chain Cover Case Shell
aliexpress.com
1,045.12 руб.
New 2021 Fox Puzzle 3D Wooden Puzzle Children Wooden DIY Crafts Animal Modeling Decompression Toys Classic Toys Wooden Puzzle
aliexpress.com
251.02 руб.
Fashion Non-Down Fleece Outdoor Gloves Touch Screen Gloves Full Finger Hand Gloves Ski Wind Protect Hands Winter Warm Gloves
aliexpress.com
1,634.87 руб.
Prom Dress for Women Beauty Strapless Slim Elegant Ladies Clothing S-shaped Sequin Sexy Hip Maxi Dresses Traf Vestidos Female
aliexpress.com
1,339.59 руб.
Gradient Print Ruffle Swimsuit High Waist One Piece Slim Bikini Backless Sexy V-Neck Beachwear Push-Ups 2022 Summer Fashion
aliexpress.com
365.27 руб.
2 Pcs Car Accessories: 1 Pcs Car Rim Wheel Bamboo Handle Mane Brushes & 1 Pcs Car Wash Cloth Microfiber Car Wash Towel
aliexpress.com
1,001.68 руб.
ZK-502T 50Wx2 Audio Receiver Amplifier Board Bluetooth-Compatible 5.0 Stereo Amplifier Module Speaker Board Subwoofer Accessory
aliexpress.com
1,095.81 руб.
2021 New Honeycomb Yoga Clothing Fitness Pants Women's Sports Running Honeycomb Leggings Peach Buttocks Sexy Leggings
aliexpress.com
876.97 руб.
Fashion Graphic Printed Long Sleeve Pullover Hoodie Men Outdoor Sport Hoodies & Sweatshirts S-5XL
aliexpress.com
374.93 руб.
10Pcs Agar Plates for Laboratory Portable Prepoured Petri Dishes Bacteria Experiment Tool Lab Agar Plate
aliexpress.ru
1,296.15 руб.
Кофейная чашка из нержавеющей стали, 200 мл, с двойными стенками, защита от разливов, товары для дома с ложкой, кофейные чашки и блюдца для наружного сада
aliexpress.ru
403.09 руб.
2pcs : Lifelike Artificial French Long Bread For Kitchen Decor Bakery Fake French Bread Display Pretend Play Food Props Set
aliexpress.ru
2,899.64 руб.
Women USB Infrared 15 Areas Heating Vest Jacket Fashion Heating Waistcoats Winter Warm Padded Sleeveless Vest Thermal Clothes
aliexpress.ru
3,741.21 руб.
GEM'S BEAUTY Original Butterfly Ear Studs Earrings For Women 925 Sterling Silver Luxury Jewelry 2022 Trend Girls Accessories
aliexpress.com
2,926.99 руб.
Покемон огонь дыхательный дракон костюм на Хэллоуин для взрослых мужчин и женщин косплей аниме мультфильм Чаризард Кигурумис наряд дракона
aliexpress.ru
3,493.40 руб.
1 комплект светодиодных указателей поворота бампера с 3 режимами освещения дневных ходовых огней ABS DRL противотуманные фары украшения для Toyota Camry 2009-2011
aliexpress.ru
1,169.83 руб.
Laid-ba Sle Свободный крой круглый трикотаж Base irt Faionable Простой дизайн Повседневный удобный длинный топ све для женщин
aliexpress.ru
78.85 руб.
Строительные блоки, аксессуары, клин «сделай сам» (левый) 3x8x2, кирпич, 1 шт., развивающая игрушка для детей, подарок на день рождения 41750
aliexpress.ru



